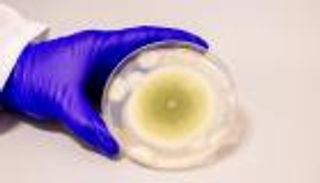
من لعنة الفراعنة إلى علاج واعد.. فطر سام يفتح آفاقا جديدة لعلاج سرطان الدم

باب إلى العالم الآخر.. اكتشاف مذهل في مقبرة أمير مصري

في كشف أثري وصفه الخبراء بـ"البوابة الكبرى إلى ما بعد الحياة"، عثر على على أكبر "باب وهمي" من الغرانيت الوردي يُكتشف حتى الآن.
قاد الاكتشاف عالم الآثار المصري الدكتور زاهي حواس، وكان داخل مقبرة أمير مصري منسي يُدعى "وسر إف رع"، نجل الملك "أوسركاف" مؤسس الأسرة الخامسة، في منطقة سقارة الأثرية.

هذا الباب، الذي يبلغ ارتفاعه 4.5 متر وعرضه 1.2 متر، لا يُفتح فعليا، لكنه كان يُعد في العقيدة المصرية القديمة رمزا مقدسا، يُعتقد أنه يسمح لروح المتوفى، أو ما يُعرف بـ"الكا"، بالانتقال بين عالم الأحياء والعالم الآخر.
أمير منسي وتفاصيل مذهلة
ما يجعل الاكتشاف أكثر إثارة هو أن هذا الأمير لم يكن معروفًا من قبل، كما يؤكد الباحث رونالد ليبرهون، أستاذ علم المصريات بجامعة تورنتو: "قبل هذا الكشف، لم نكن نعلم بوجود هذا الأمير على الإطلاق".
وتحمل نقوش الباب الوهمي مجموعة من الألقاب الرسمية التي تعكس مكانة الأمير البارزة، منها: "الأمير الوراثي، حاكم منطقتي بوتو ونخبت، الكاتب الملكي، الوزير، القاضي، والكاهن المرتل".

غرانيت نادر وطقوس خالدة
بعكس معظم الأبواب الوهمية المصنوعة من الحجر الجيري، فقد نُحت هذا الباب من الغرانيت الوردي النادر المستخرج من أسوان، ما يشير إلى الامتياز الملكي لصاحبه، وإلى حجم الموارد التي خُصصت لضمان راحته في الحياة الآخرة.
كما عُثر بجانبه على 13 كرسيا منحوتا من نفس الغرانيت الوردي، بالإضافة إلى مائدة قرابين قطرها نحو 92.5 سم، منقوش عليها مشاهد تقديم الأضاحي، وتمثال أسود ضخم لشخص مجهول، يرجّح أنه دُفن لاحقًا في المقبرة.
بين العالمين
توضح الباحثة ميلاني بيتكن من جامعة كامبريدج أن الأبواب الوهمية كانت تُستخدم في الطقوس الجنائزية، حيث يتردد الأقارب والكهنة لقراءة اسم المتوفى وتقديم الطعام والشراب، في حين يُعتقد أن "الكا" كانت تتنقل من خلالها لتتغذى على تلك القرابين في العالم الآخر.
وتقول "إنه رمز لبوابة روحية حقيقية، تربط بين عالم الأحياء والموتى".
البحث مستمر
ورغم هذا الكشف الكبير، لم يُعثر بعد على غرفة الدفن الفعلية للأمير، ويواصل الفريق الأثري أعمال التنقيب، على أمل العثور على مومياء الأمير أو تابوته الحجري.
وفي انتظار ذلك، يظل هذا الباب الحجري المهيب واقفا كـ"صامت مقدس"، يروي حكاية أمير منسي، وسعي خالد نحو الخلود.